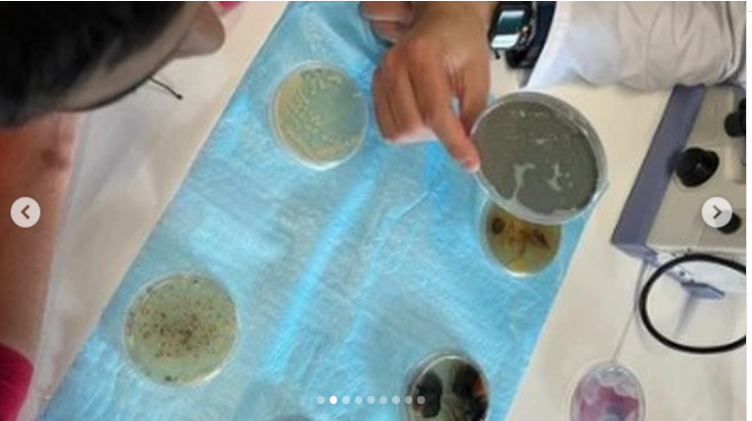

Dia Internacional do Microrganismo
No passado dia 28 de outubro, recebemos no nosso Agrupamento, na sala do CCVnE e na sala de CN da EB1, uma equipa de investigadoras e alunos do Centro de Investigação em Ciências da Saúde da Universidade da Beira Interior (CICS-UBI) para dinamizar atividades com alunos de 6.º e 4.º anos.
O Dia Internacional do Microrganismo foi, assim, assinalado com atividades lúdico-científicas, durante as quais os nossos alunos puderam aprender de forma divertida sobre bactérias, fungos e vírus, com experiências cheias de descobertas, percebendo como os cientistas estudam este fascinante mundo invisível a olho nu.
Foi sem dúvida, uma excelente oportunidade para aprender sobre os seres microscópicos que vivem à nossa volta e que têm um papel fundamental na saúde e no ambiente.
O nosso muito obrigado ao grupo fantástico do CICS-UBI pela excelente partilha de conhecimento.